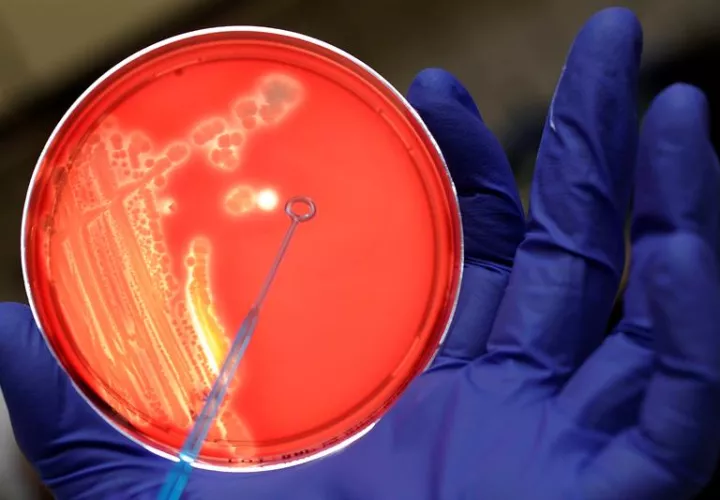

Bacterias proliferan de forma organizada
Una investigación demuestra que las infecciones del Staphylococcus aureus se organizan en subpoblaciones de bacterias especializadas en romper tejidos, secretar toxinas, adherirse a órganos o combatir al sistema inmune.
Las bacterias de una infección no se extienden de manera desordenada, sino que lo hacen organizadamente y con una misión concreta: unas se dedican a secretar toxinas, otras se adhieren a órganos, y otras combaten al sistema, entre otras funciones.
Esta es la principal conclusión de un estudio publicado en la revista eLife y en el que han participado científicos del Consejo Superior de Investigaciones Científicas (CSIC) de España.
Siempre se ha creído que las bacterias son organismos relativamente simples, que generan infecciones complicadas solamente aumentando excesivamente su número, lo que impide a los antibióticos erradicar completamente en una infección.
Sin embargo, el estudio ha demostrado que estos microorganismos están altamente especializados en una labor concreta.
"En esa comunidad, todas las bacterias son genéticamente iguales, pero hay subpoblaciones que expresan sus genes de manera diferente y esto deriva en su especialización para realizar un trabajo concreto", explica Daniel López, investigador del Centro Nacional de Biotecnología y director del estudio.
El trabajo demuestra que las infecciones del Staphylococcus aureus se organizan en subpoblaciones de bacterias especializadas en romper tejidos, secretar toxinas, adherirse a órganos o combatir al sistema inmune.
"Todas coordinadas entre sí con el fin generar una infección exitosa; como si se tratase de "ciudades de microbios", donde existe una división del trabajo; médicos, abogados, policías, tenderos, fontaneros... Todas son profesiones importantes para mantener un equilibrio y hacer que una comunidad progrese y sea productiva", detalla López.
Sin embargo, algunas subpoblaciones son más importantes que otras, según el tipo de infección.
"Las bacterias especializadas en combatir al sistema inmune son esenciales durante infecciones crónicas mientras que las que secretan toxinas son esenciales para desarrollar infecciones agudas; al igual que en tiempos de guerra, la profesión militar es esencial para la supervivencia de una comunidad, o el personal sanitario durante una epidemia", explica López.
El hallazgo ayudará a generar terapias contra infecciones difíciles de tratar y diseñadas para eliminar solamente la subpoblación que sustenta a la infección.
Otras aplicaciones de este modelo de proliferación bacteriana están siendo consideradas; por ejemplo, para predecir el comportamiento de países frente a situaciones de estrés, desde una crisis económica a un terremoto.